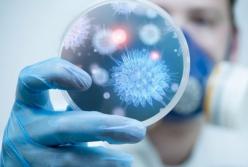
Действовать методом кнута в период коронакризиса недопустимо

Виктория Гриб
Все публикации Виктория Гриб
Действовать методом кнута в период коронакризиса недопустимо
Действовать методом кнута в период коронакризиса недопустимо
С понедельника 22 июня в Украине вступает в силу новая методика определения эпидемиологической ситуации в конкретном регионе, от которой зависит ужесточение карантина.
 Шаг в сторону от кризиса. Украинский уголь снова востребован!
Шаг в сторону от кризиса. Украинский уголь снова востребован!
Новость, которую очень ждали все шахтеры и теплоэнергетики! Украинский уголь будет основным видом топлива для производства электроэнергии! Только что сообщил премьер Шмыгаль.
 ТКГ – это не только политика. Это еще и экология и социалка
ТКГ – это не только политика. Это еще и экология и социалка
Эфир на телеканале «НАШ» свел меня с Сергеем Гармашем. Вместе с Денисом Казанским он представляет неподконтрольную часть Донецкой области в Трехсторонней контактной группе в Минске.
 Горняки – на пределе. Угольную отрасль нужно спасать немедленно
Горняки – на пределе. Угольную отрасль нужно спасать немедленно
То, что я услышала в Доброполье – это даже не боль и не ужас. Это крик отчаяния от безысходности. Горняки уже на пределе!
 Украине необходима качественная система народовластия
Украине необходима качественная система народовластия
Зеленский внес на рассмотрение парламента законопроект «О народовластии через всеукраинский референдум». Законопроект определен как неотложный.
 Мы не имеем права бросать шахтеров на произвол судьбы
Мы не имеем права бросать шахтеров на произвол судьбы
Когда в апреле Минэнерго разработало новый энергобаланс, появилась надежда, что кризис в энергетике будет преодолен.
 Энергетическая стабильность – вопрос национальной безопасности
Энергетическая стабильность – вопрос национальной безопасности
Заявление секретаря СНБО Алексея Данилова о необходимости срочных решений для сбалансирования работы рынка электроэнергии – это еще один жирный восклицательный знак в повести о катастрофе украинской энергетике.
 Переход к электронным трудовым книгам. Плюсы и минусы
Переход к электронным трудовым книгам. Плюсы и минусы
Кабинет Министров на заседании принял решение направить в парламент законопроект, который предусматривает переход к электронным трудовым книгам.
 Шахты Доброполья в простое. Кто виноват и что делать.
Шахты Доброполья в простое. Кто виноват и что делать.
Мне очень непросто писать эти строки, и я до последнего надеялась, что новости из Доброполья будут радостными, но увы… Сегодня поступила информация о том, что шахты Добропольеугля и ЦОФ Октябрьская останутся в простое после 1 июня.
 Кабмин обязан позаботиться о детсадах в период пандемии
Кабмин обязан позаботиться о детсадах в период пандемии
Дорогие чиновники Кабмина, в особенности, Минздрава и Минобразования. Странная штука получается.
 Два президентских срока или один? Почему Зеленский изменил свое мнение
Два президентских срока или один? Почему Зеленский изменил свое мнение
Баллотируясь в президенты, Владимир Зеленский неоднократно говорил, что идет только на один срок. А во время пресс-конференции допустил, что одной каденции ему не хватит.
 Как заставить себя уважать, если тебе не доверяют?
Как заставить себя уважать, если тебе не доверяют?
Однажды этот вопрос у меня возник во время неформальной беседы с другом из Европы. Мы говорили об экологии, но он неожиданно заговорил об отношении граждан Евросоюза к украинцам.
 Итоги Антикризисного энергетического штаба
Итоги Антикризисного энергетического штаба
Проанализировали уровень выполнения решений, принятых на предыдущем заседании штаба. К сожалению, практически по каждому есть вопросы.
 Не ищите «зраду» в новом энергобалансе
Не ищите «зраду» в новом энергобалансе
Невероятно устала от искателей «зрады» там, где ее априори не существует.

 Атомную генерацию уничтожают: правда или вымысел?
Атомную генерацию уничтожают: правда или вымысел?
